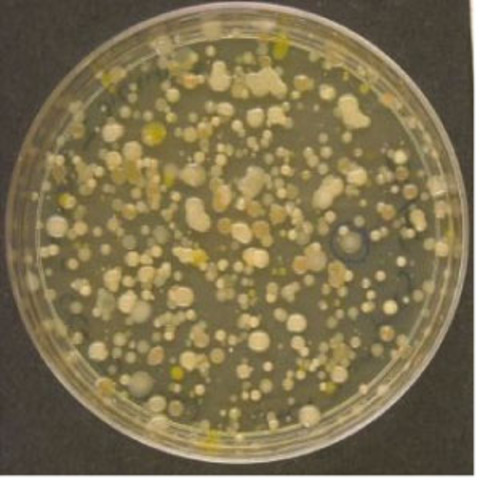
Made a Nutrient Agar Plate

-
Poured milk intio vial and tested for temperature, PH, color, texture, and volume
Temperature:13 C
PH level: 6
Color: White
Texture:Liquid
Volume:125ml -
-
The milk never got chunky or solid it just smelled rotton.
-
Checked temperature, ph level, color, texture, and volume
Temp: 24.3 degrees celcius
PH: 7
Color: white
Texture: liquid
Volume: 125mL -
We took a nutrient agar plate and mr baker poured a hot substance and let it sit for 24 hours
Temp: 23.9 degrees celcius
PH: 7
Color: White
Texture: liquid
volume: 125mL -
After we let it sit it became a gelatin like substance which we added milk to and put in the incubatore to heat the milk and cause it to grow a fungus to study in a microscope
Temp: 23.6 degrees celcius
PH: 7
Color: white
Texture: liquid
Volume: 125mL -
Used purple stain to color the milk bacteria so we could study them more thoroughly using the high powered Microscope We observed a weby complex system of cells bunched together and they didnt move
Looking for a timeline maker?
Create timelines for projects, roadmaps, history, lessons, legal cases, and stories with Timetoast. Timetoast is a timeline maker for work, school, research, and stories.